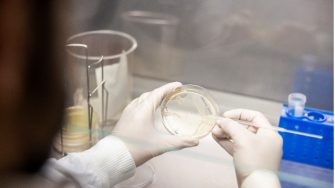
Kaakoush Group: Host-Microbiome Interactions

Microbiome, Infection, Immunity and Inflammation |
Faecal microbiota transplantation (FMT) substantially modifies the microbiota of a recipient, thus proving effective at treating diseases where dysbiosis contributes to aetiology. Treatment of Clostridioides difficile infection (CDI) has been revolutionised by FMT (>90% success). While to a lesser extent than CDI, FMT has shown success (30-50%) in treating the inflammatory bowel disease, ulcerative colitis (UC). Moreover, FMT holds promise at treating another form of colitis, that caused by immune checkpoint inhibitors (ICI) used to treat cancer. Despite our capacity to refine donor selection, FMT remains a blunt tool with numerous uncontrolled variables. Therefore, the goal of our team is to identify microbial and host components contributing to treatment response, allowing the development and transition to defined microbial therapies.
Current projects
Defined microbial therapeutics for colitis
Our team leverages our extensive collection of patient and donor samples from two randomised clinical trials on FMT in UC [Lancet & Lancet Gastroenterol Hepatol], our cohort study on FMT in primary and recurrent CDI [mSystems], and our new randomised clinical trial on FMT in ICI colitis, to identify donor-derived bacterial strains and functions and host biomarkers associated with therapeutic responses. The microbial and host signatures we identify through shotgun sequencing, machine/deep learning analysis, microbial culture, and host-microbial interaction studies are validated in pre-clinical mouse models using transplants with donor-derived defined microbial consortia.
Collaborative projects
Our team has a substantial network of local, national, and international collaborations investigating the role of microbial communities in a variety of contexts. These include several projects on gastrointestinal cancers, metabolic syndrome, effects of resistance training, autoimmune diseases, preterm birth, cystic fibrosis and regulation of innate immune responses to pathogens.
Our experts
Scientia A/Prof Nadeem Kaakoush - Group Leader
Scientia A/Prof Nadeem Kaakoush is an internationally recognised researcher leading a team that investigates host-associated microbial communities. His team pioneered methods to manipulate these microbial communities to treat disease. His independent research journey started when in 2011, he was awarded a NHMRC Early Career Fellowship (2011-2014) to study the microbiota in inflammatory bowel diseases. Later, his interests expanded to the microbiome in upper gastrointestinal cancers, and in 2016, he was awarded a Career Development fellowship from the Cancer Institute NSW, and consequently, he relocated to the School of Biomedical Sciences. In 2019, he was awarded a highly competitive UNSW Scientia appointment to expand his work on the microbiome, and to date, he has published >140 peer-reviewed outputs accumulating >13000 citations, with his research being highlighted in journals such as Nature and Lancet.
Team members
- Dr Marwan Majzoub
- Isidora Simovic
- Shreeya Raich
- Md Mushahidul Islam Shamim
- Isabelle Daly
Associated academics
- A/Prof Natalia Castaño-Rodriguez
- Prof Nicodemus Tedla
- A/Prof Craig Haifer
- Prof Margaret Morris
- Dr Frances Byrne
- Dr Hamid Alinejad-Rokny
- Dr Shafagh Waters
- Dr Mandy Hagstrom

